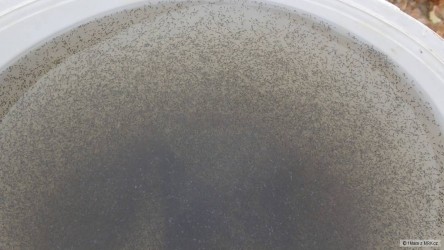

- Úvod
- Pokec
Můj lov
- Zobrazit vybrané uživatele.
načítám...
0x v oblíbených a 9x v ignorovaných.
mdx - Profil | Ne 18.3.2018 10:58:55
Zkouška nového objektivu dopadla na jedničku. Konečně zase jeden víkend podle mého gusta.
dizlektik fídža - Profil | So 17.3.2018 19:41:46
pavel.1 - Profil | So 17.3.2018 17:44:16
Tak nám napadl sníh , tak jako obvykle zkouším chytit kapra na sněhu , letos na to mám štěstí a opět se to povedlo . Vzal jsem si jen krátké třiceti gramové vláčáky , s většíma očkama , aby mi očka nezamrzaly . Většinou jde o jeden záběr , ale dneska jich bylo víc . Ještě jeden kolem 70 cm mi vypnul . Krásná chytačka , nikde ani noha , prostě to v zimě miluju a když se povede ještě tohle tak je to super , Fotil jsem i nejmenšího jelikož jsem si myslel že bude jediný . 30 , 40, 67 , 79 cm 10,9 kg . Fotáku se nechtělo moc spolupracovat , ale aspon něco .
potočák 62 - Profil | So 17.3.2018 17:29:17
Dneska počasí hrozný a najet v tom 350 km žádná legrace ale přeci nenechám 1Maru ,aby se pořád vytahoval s těma mníčkama.Když je má on,tak já taky a ted´ se ukáže.Petrův Zdar
VL.K. - Profil | So 17.3.2018 15:55:40
Do rána pěkně nasněžilo, přesto jsem to šel zkusit a zahájit....nasadil jsem Centrepina, dikobrazí brčko a hurá k vodě...pár rybek se povedlo,ale největší hlad měla nutrie,která mi skoro vlezla do tašky....
1Mara - Profil | So 17.3.2018 15:10:23
Dneska jsme se konečně dočkali vysazení mníčka na letošní rok. Snad se mu bude dařit dobře, jako těm loňským mníčkům. Prachový plankton tam má tak teď už jen doufat, že se během roku do podzimu nic vážného nestane a s lovíme ho alespoň v takovém množství, jako loni :-)
dvorak002 - Profil | So 17.3.2018 11:03:30
Včera po práci rychle k vodě než přituhne.Vydržel jsem tam od 14:30 do 17:00 než začalo pršet.Změnil jsem trošku složení krmení a bylo to znát místo cejnů to bylo většinou o kapříkách.Chvílema jsem nestíhal 2 pruty.Povedlo se cca 15ks kapra a 10ks cejna a sem tam nějakej cejnek.Něco popadalo.
návazec: 0,14
délka návazce: 20cm
nej. nástraha: mastňák,hnoják,kuku s červem
návnada: Lorpio černá plotice+strouhanka+hlína+rozmixovaná kukuřice+melasa+červy
MV fishing - Profil | Pá 16.3.2018 14:31:32
nicminebere - Profil | Čt 15.3.2018 20:47:47
Theodorik - Profil | Čt 15.3.2018 19:27:32
Dnešní hodinka a půl po práci,nádhera,šli hlavně parmy,podoustve i jelec.Absťák uspokojen,čudly se napapaly zbytků mastňáků.
kmenový vlasec: 0,16mm
velikost háčku: 12
nej. nástraha: Mastňáci
jeden3 - Profil | Čt 15.3.2018 15:41:43
dnees bylo u vody sice krasne,ovsem velmi vetrno,spicky tancily v tom vetru lambadu a rybky mi beztestne konzumovaly cerviky z hacku :-)) jinak bylo krasne slunecno,tak jsem alespon vyvetral sebe a vybavu.
Červené karty: mekvak, Dalimil, Petras, start1406, hadman1, ajsa, mazak, Saxafon, BLACKHAMER, jarysek120, t1ran, gunč, KiKSo1, smellslike, Rybovrah 1, Karlosak, bigfatcatfish, šmudla007, TomH, tupac, Gorylix, Fredex, Heineken***, Heineken*****, Hein*eken, SKFishing, masák11111, ryby-zabiju, Masařmasařů, carp1990, HameB01, Hazz, Pazz, Lojzakk, mickyracers, Malanchoe, Lostoros, kkt, RYBOVRAH FOREVER, Nornik-K, OtaLakatos, nornik-l, nornik-m, nornik-o, VlasLakatos, HugoStiglitz, Akéla, nornik-y, loupeznik007, Bugun, Had.
Kde to žije - všechna témata
17:35Zákaz vstupu a rybolovu v revíru Dyje 13/1 - ohrožený orel (Bleskovka) 33
17:28Rybáři porušují pravidla. Porybní na Plzeňsku hlídají i z lodě. (Bleskovka) 3
17:18Velké zlepšení čistoty vody má háček - řekami tečou tuny neviditelné špíny (Bleskovka) 34
12:49Energetika vs. divoká voda: Kdo má větší nárok na naše řeky? (Bleskovka) 14
12:08Brzda na navijáku Shimano Ultegra xr 14000 xtd 7
10:34Výběr prutu sportex. 186
ČtRybáři a Hi-fi, High end elekronika 823
ČtRealita po zimním náletu kormoránů. 48
ČtŠVÉDSKO Sundholmen 2026 0
ČtHlásiče MAD HI-T Bite alarm 3+1 27
ČtRybáři a vinařství 888
ČtLabe z přelomu března a dubna nám dalo zabrat (Video) 37
ČtPoradna: Redakce MRK.cz 1751
ČtGalerie muškařských navijáků 594
ČtVakuování vařeného partiklu 31
Co je nového - všeobecné
11:59Bleskovka: Rybáři porušují pravidla. Porybní na Plzeňsku hlídají i z lodě.
StBleskovka: Energetika vs. divoká voda: Kdo má větší nárok na naše řeky?
ÚtBleskovka: V Nizozemsku pomáhají lidé rybám překonat vodohospodářské stavby pomocí "rybího zvonku"
PoBleskovka: Velké zlepšení čistoty vody má háček - řekami tečou tuny neviditelné špíny
SoBleskovka: Zákaz vstupu a rybolovu v revíru Dyje 13/1 - ohrožený orel
. . . Bleskovka: Úhyn pstruhů v Litavce: Rybáři viní otevřené stavidlo a nedostatek vody v korytě
Akční nabídky
DAM naviják Quick Intenze FeederZa 1.350 Kč
Navijáky DAM QUICK INTENZE FD FEEDER jsou navrženy s velkým důrazem na detail a zajišťují velmi hladký a silný chod - jsou vhodné pro použití na lehký i težký feeder.
ČASOVĚ OMEZENÁ AKCE! Lehátko Mivardi CamoCODE Flat6Za 3.750 Kč
Extrémně lehké, velké a 100% ploché lehátko ve velice atraktivním designu s digitálním maskováním.
Oznámení - obecné
Na toto místo můžete sami vložit své oznámení ostatním čtenářům MRKu.
Kalendář akcí - obecné
24.4.Self made Fish cupZrušeno
25.4.Jarní rybářské závody na...
25.4.Lanškroun - tradiční rybářké...
25.4.Rybářské závody Domažlice 2026
25.4.Pohár Poseidona
25.4.rybářské závody Trojice Jaroměř
25.4.Tradiční rybářské závody v...
25.4.Rybářské závody v Myslíně
25.4.Přísnotické rybářské závody
25.4.Rybářské závody na rybních pod...
Doporučujeme e-shop
GScarp.cz
Rádi Vás kdykoli uvítáme na našem internetovém obchodě rybářské potřeby a nově i v naší kamenné prodejně. V našem...